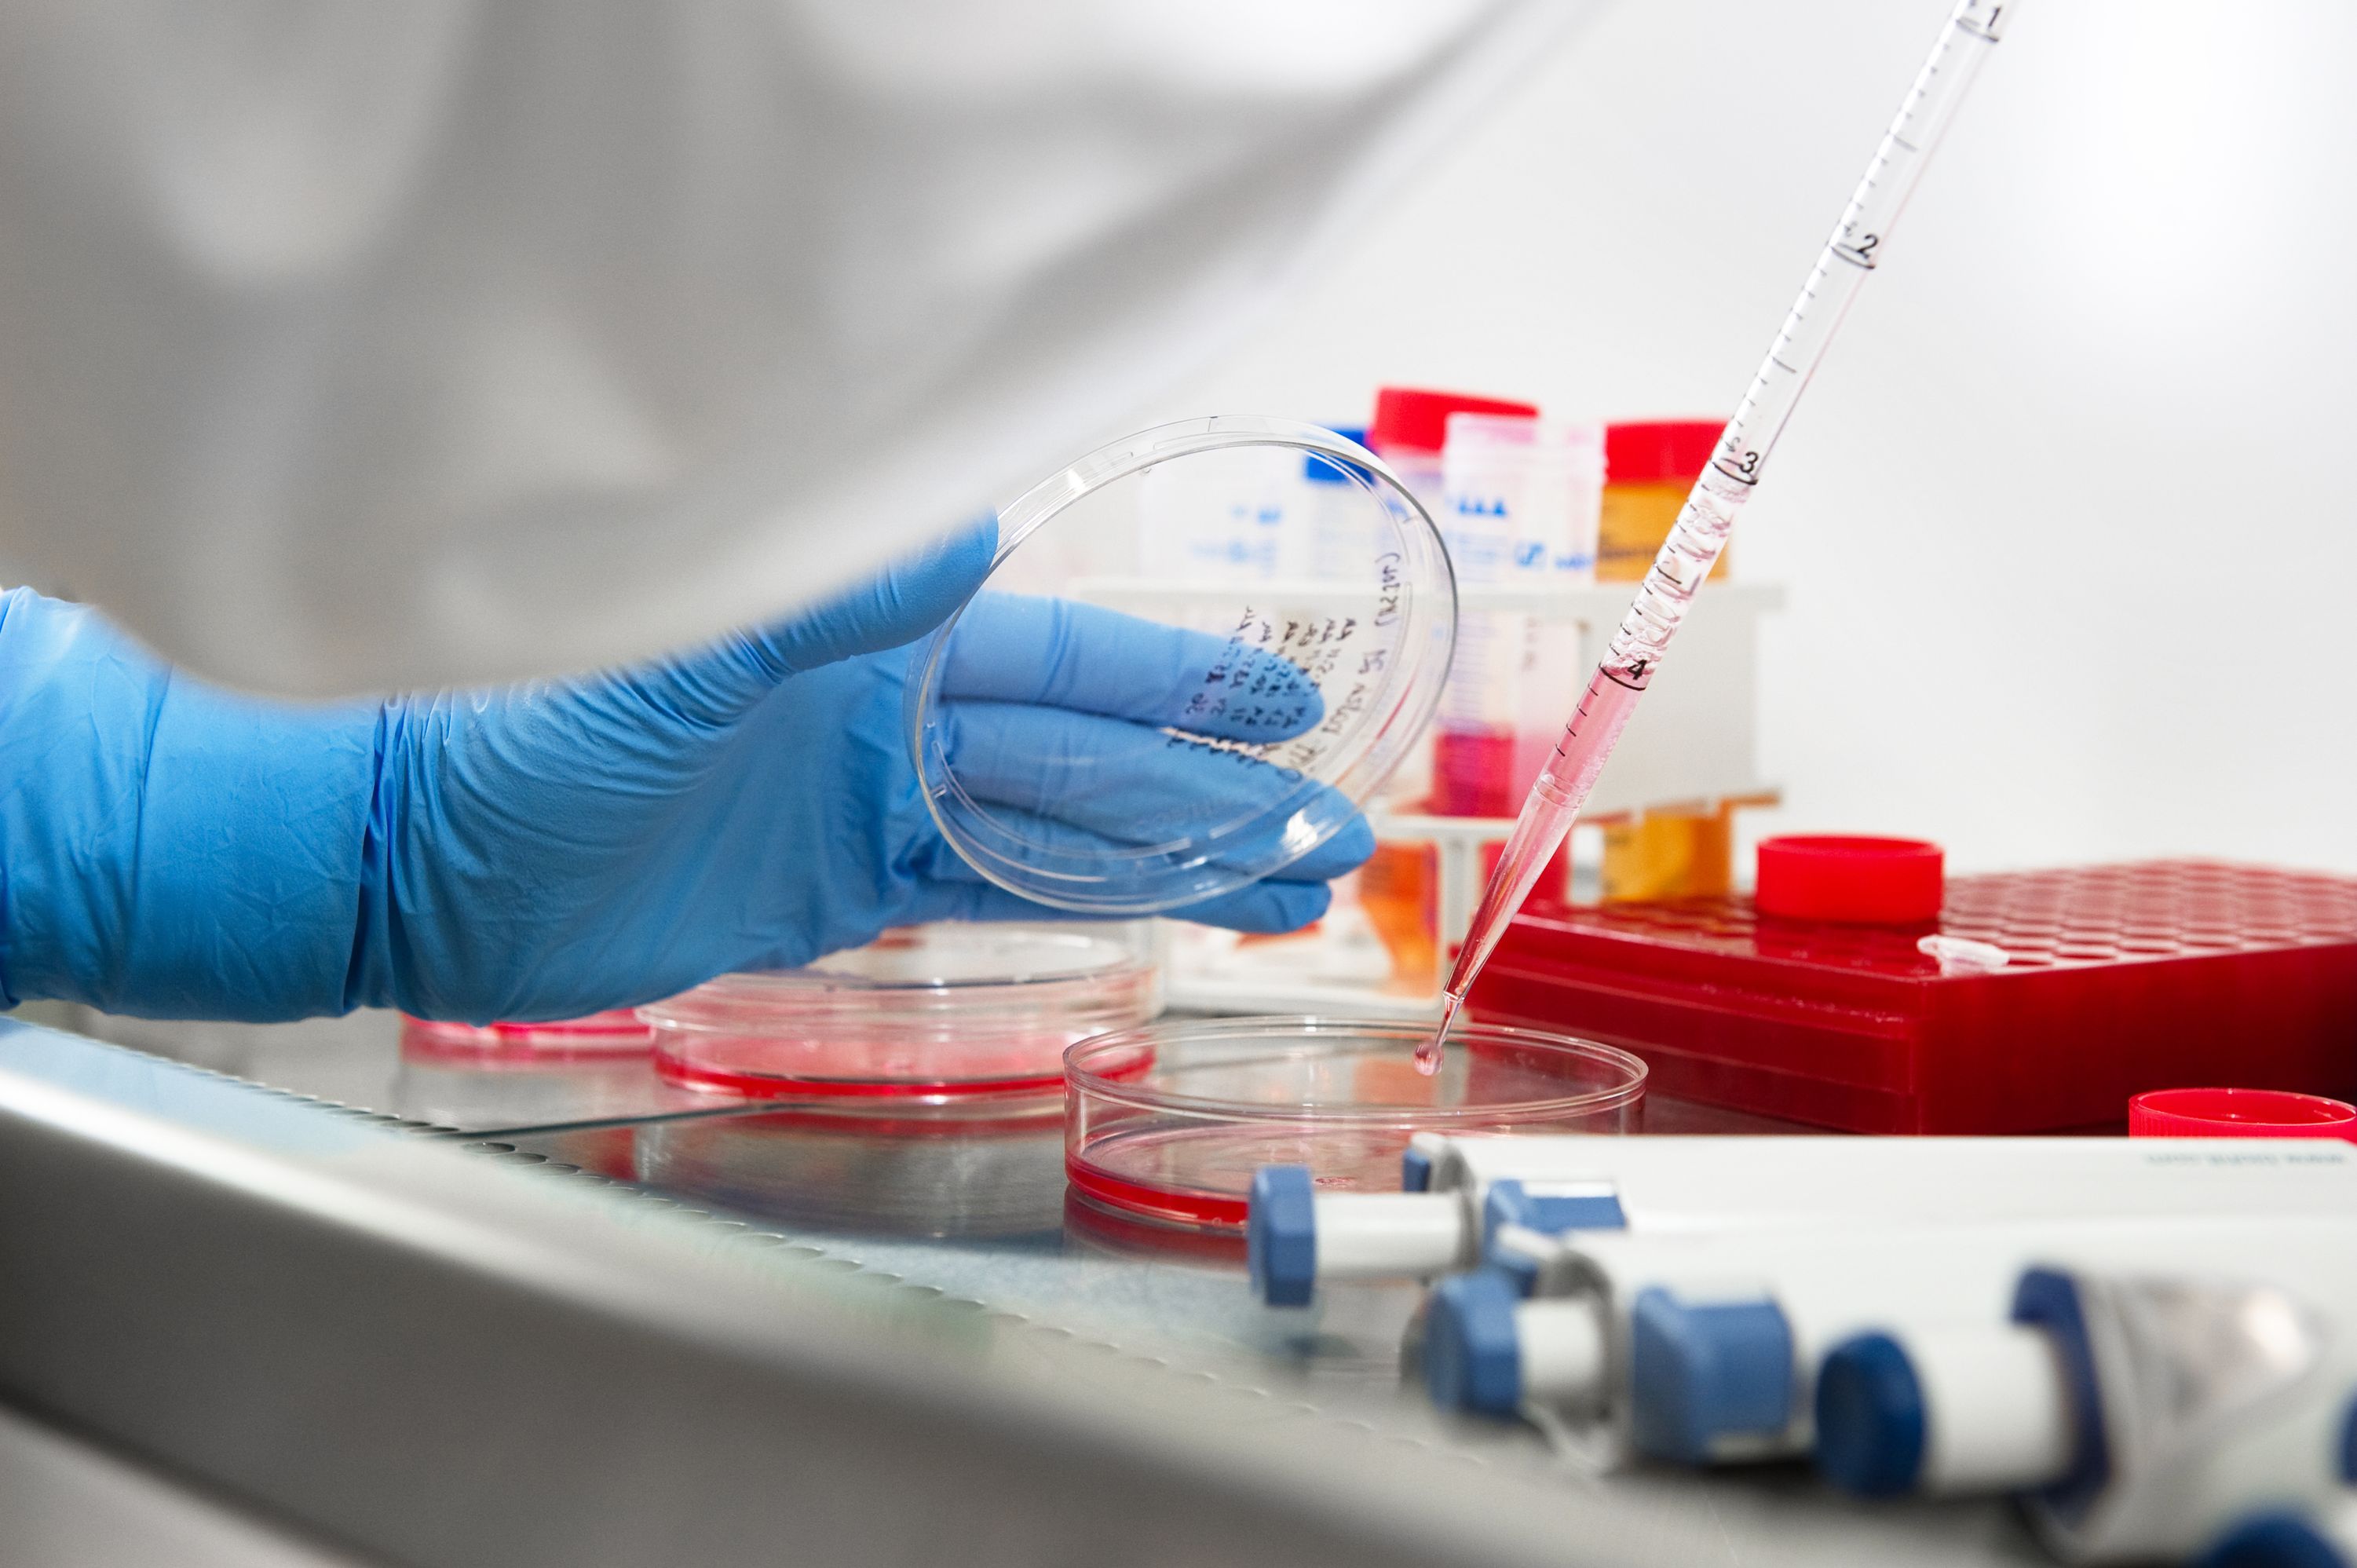

Calotte Academy 2026: Intelligence
Mon, Jun 08, 2026


Seizing a sustainable future
The University of Eastern Finland is one of the largest universities in Finland. We show courage in crossing academic boundaries and our interdisciplinary approach is internationally recognized. Our research is ranked among the best in the world in several fields. As a multidisciplinary university, we train experts for the various sectors of society. We seek solutions to global challenges through multidisciplinary research and education. In collaboration with our partners, we generate new knowledge, expertise and innovations.
Our goal is to be ranked among the leading 200 research universities in the world and, in the strong research areas, among the world's leading 50 research universities.
Our campuses are located in Joensuu and Kuopio. We are home to approximately 15,500 students and 2,500 members of staff.
Multidisciplinary, renewal-driven and international research
Research carried out at the University of Eastern Finland is of a high international standard and has significant impact, with an emphasis on interdisciplinarity. We have identified four global challenges for which we seek solutions through our interdisciplinary research and education.
These challenges are:
Ageing, lifestyles and health; Learning in a digitised society;Cultural encounters, mobilities and borders; and Environmental change and sufficiency of natural resources.
A student-centered university with a high-quality learning environment
UEF is a multidisciplinary university, which offers teaching in more than 100 major subjects. We have four faculties: the Philosophical Faculty, the Faculty of Science and Forestry, the Faculty of Health Sciences, and the Faculty of Social Sciences and Business Studies.
The University of Eastern Finland puts students, high-standard learning processes and student well-being first. We seek to be the best academic learning environment in Finland by 2020. We are a sought-after place to study thanks to our teaching, which is based on the latest research and our diverse education offering, as well as our flexible study opportunities. Our graduates acquire the skills required by the changing labour markets and international operating environments.
We have extensive international relations and are involved in several international networks. Our teaching and research staff and students are active in participating in various mobility programmes. We have concluded bilateral agreements of cooperation with approximately 100 universities abroad.
A responsible social actor
We are known as a partner who takes the initiative, and as an influential participant in social dialogue. We engage in close cooperation with various research institutes, businesses and industries. We are a builder of open innovation ecosystems and we promote the emergence of new business activities in eastern Finland in particular. Our researchers produce data to support societal decision-making and they participate in the work of several working groups in different fields.

Mon, Jun 08, 2026

Thu, Mar 26, 2026

Mon, Mar 23, 2026